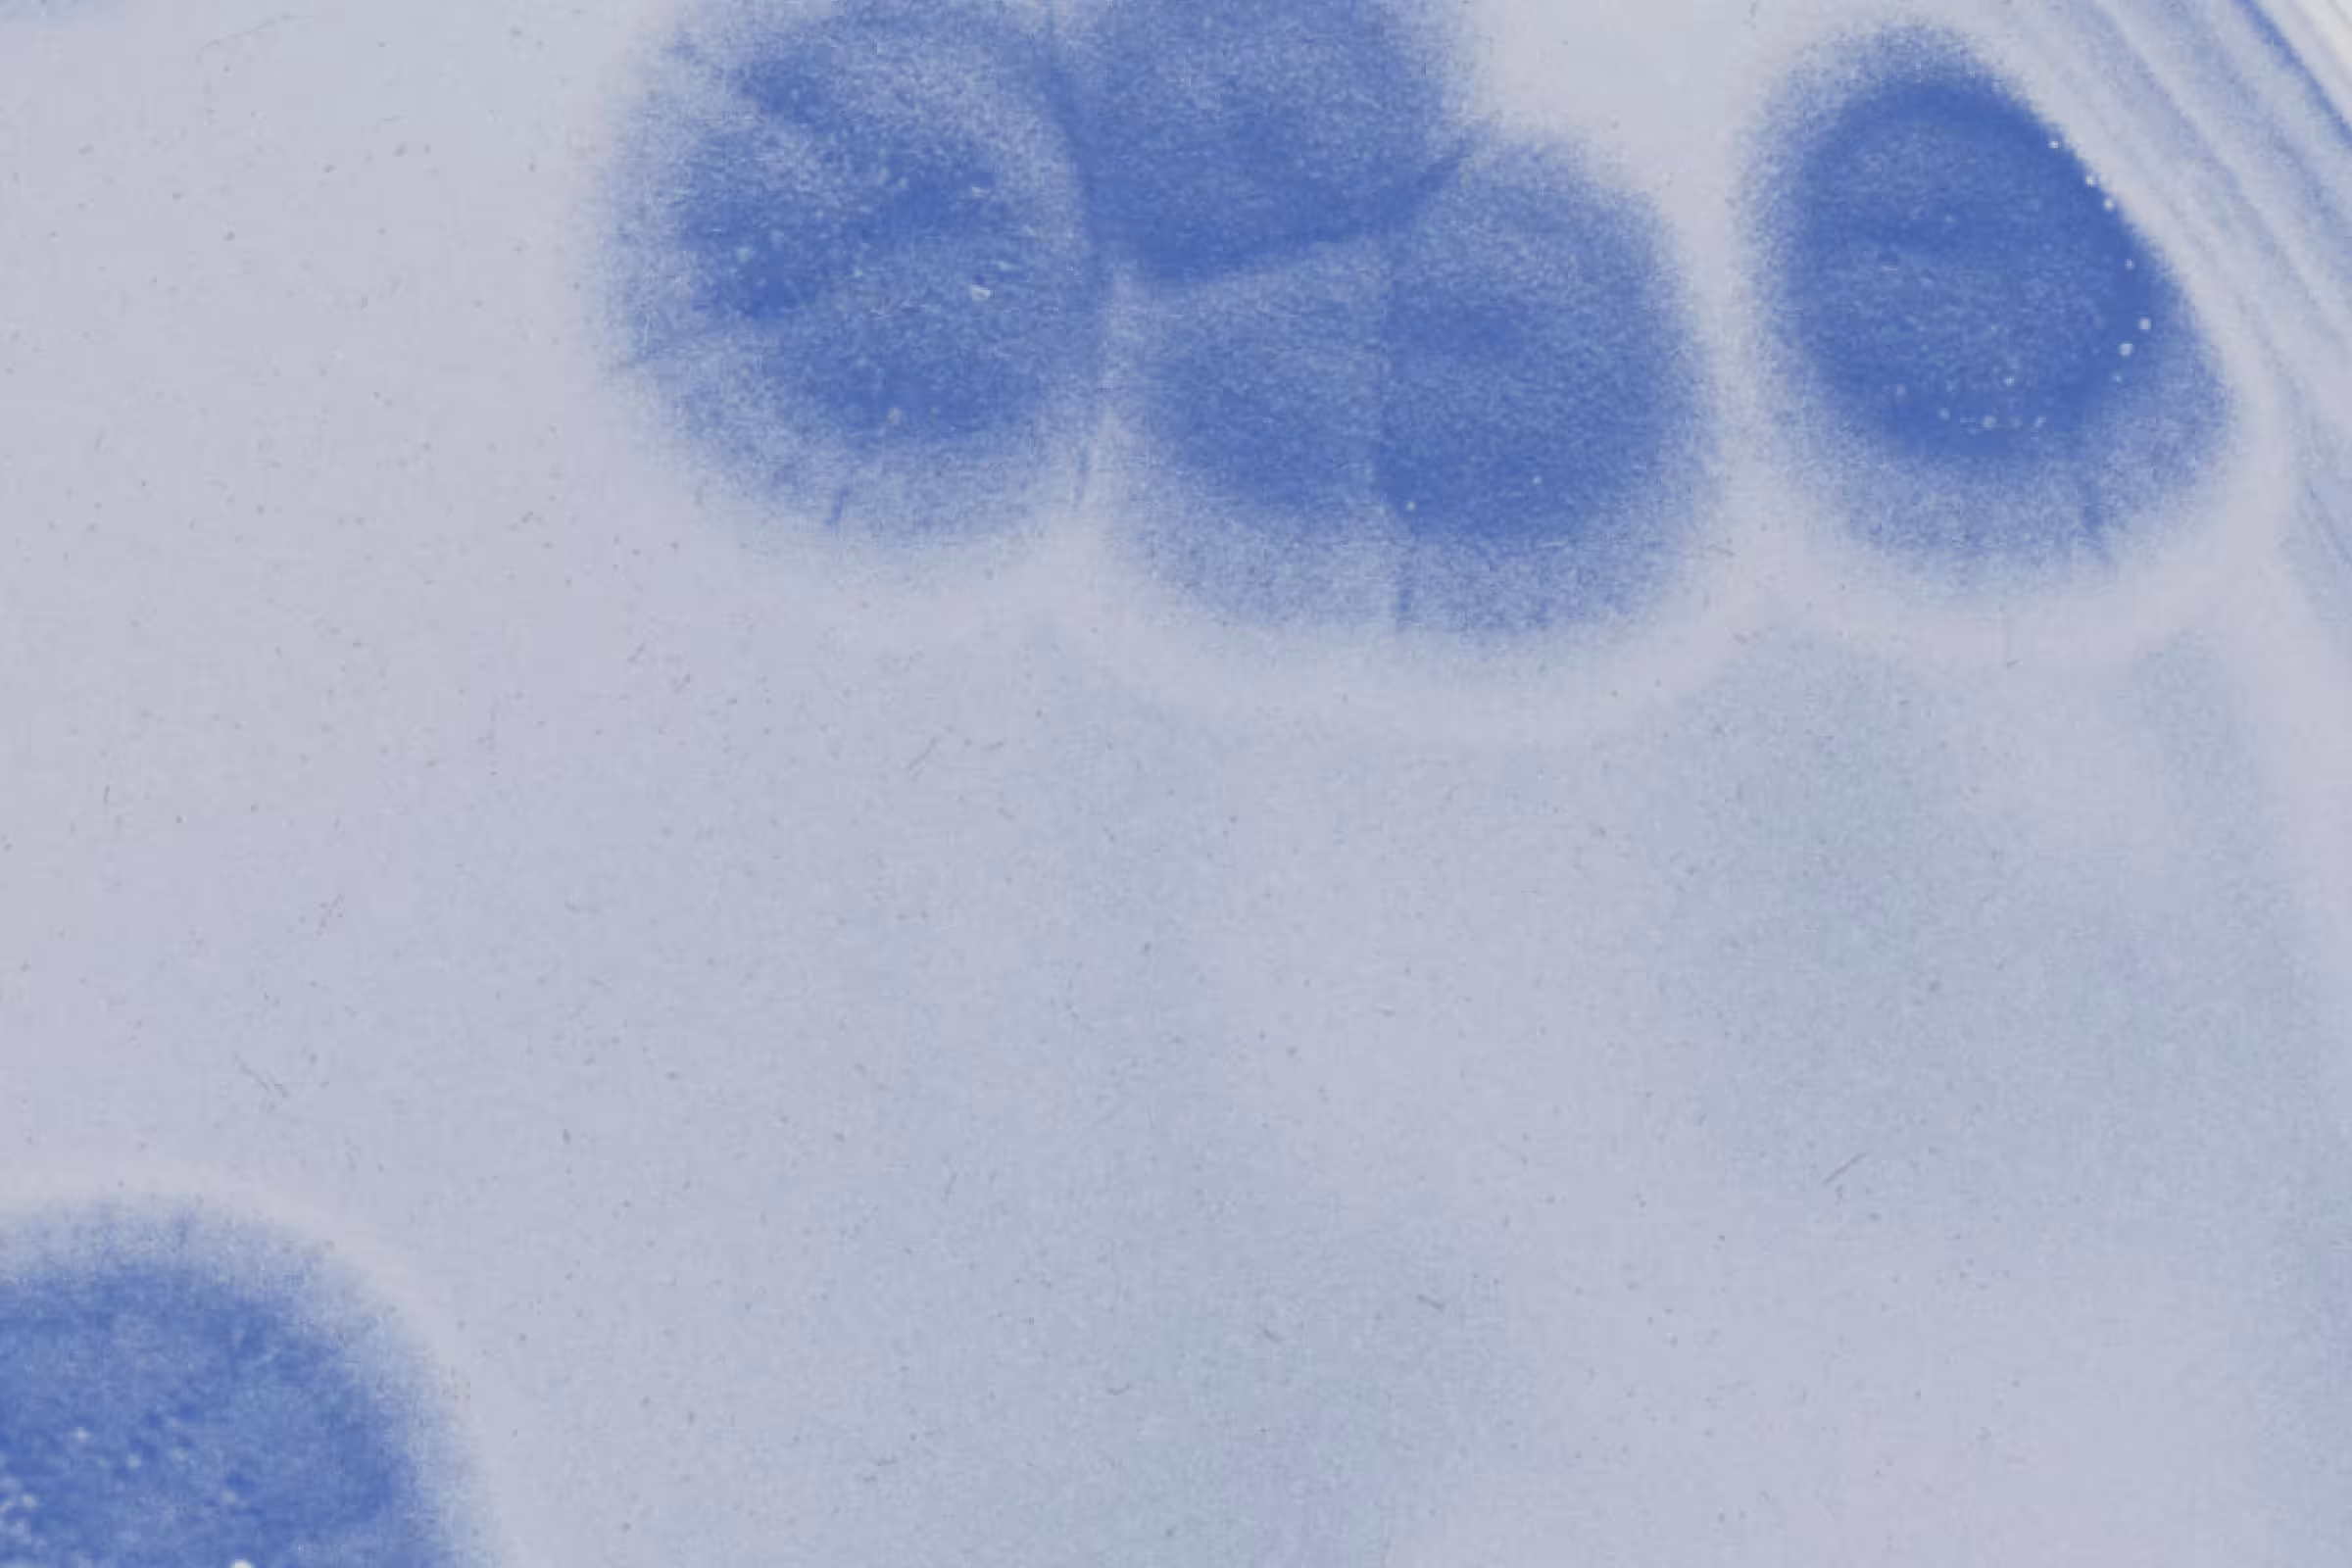

Dr. Krystal Thomas-White, PhD
Dr Thomas-White is a microbiologist specializing in the female urogenital microbiome and how it relates to health and disease. In under 10 years she has over 20 peer-reviewed articles that have been cited over 1000 times. Her research explores how alterations in both the bladder and vaginal microbiomes are associated with common disorders (like UTIs, bacterial vaginosis, and incontinence) and how the microbiome changes in response to hormones throughout life, particularly during prengnacy, and menopause. As senior scientist at Evvy she is excited to help bridge the gender health gap, and provide women with insight into a part of their bodies that has been too often overlooked.